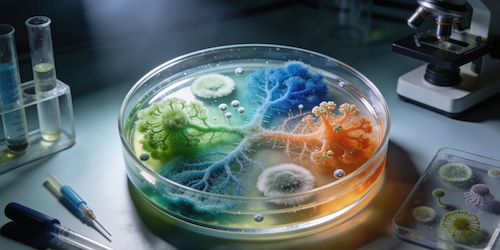
Next generation fungal diagnostics

Overview
The COVID-19 pandemic had a tremendous, negative impact on society and healthcare systems globally. The speed of the response from all quarters was unprecedented, as was the level of cooperation within and around the scientific community. This helped to minimise the impact of the pandemic as much as possible. The scientific community is now focused on ensuring that the response is even faster for future pandemics, so that we can further mitigate the effects. The best way to achieve preparedness for future pandemic is to invest in it now. In part, future pandemic preparedness means ensuring that resources developed during the COVID-19 pandemic are kept up-to-date and ready for immediate use in the next pandemic. This will reduce the time and effort required to reuse these resources during the next pandemic.
This section of the Swedish Pathogens Portal is dedicted to capabilities related to pandemic preparedness (i.e. services or resources that can be used in current and future pandemics). At present, the capabilities listed are primarily related to the Pandemic Laboratory Preparedness (PLP) program at SciLifeLab (refer to our PLP program background page for additional information). However, any pandemic preparedness capabilities built by individuals associated with a Swedish university or research institute can be included.
The pages for each capability are regularly updated with new information as it becomes available.